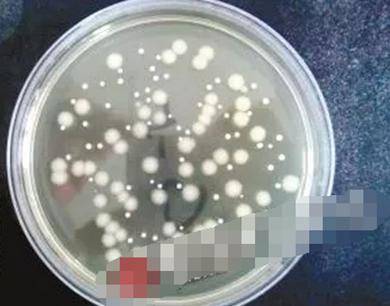

枕头是每晚都会亲密接触的东西
我们头上的油脂、灰尘、头屑、汗液
都会一点一点留在枕头上

我们经常会换洗枕巾、枕套
但是你洗晒过你的枕芯吗
枕头细菌有多少?
有媒体做过一个实验
针对 5 种枕芯
这些枕头使用时间 1 年左右
广告而且从未被清洗过
一个白点就是一个菌落
实验结果显示细菌都超标!
除了细菌
5种枕芯都含有螨虫及螨虫尸体

显微镜下的螨虫
枕头螨虫有多少?
有电视台曾选取了3个枕头进行实验
在中国科学院动物研究所
进行了螨虫测试
结果如下

枕头使用须知
1枕头不要混用
家中的枕头应该专枕专用,以避免螨虫、细菌交叉感染。为了不易生菌,选择枕套时,应该选择纺织较疏松的材料。
2枕芯要常清洗
枕头也要像我们日常穿的衣服一样,经常洗、经常晒,保养好。如果条件允许,最好床上用品每周用55℃的热水洗涤。
广告化纤枕芯
透气性差,长时间使用后易缺乏弹性,变形结块。清洗时注意选用温和的洗涤剂,如果机洗,最好包一块大毛巾,以均衡水流,防止变形。可以适当晾晒,避免暴晒。
荞麦皮枕芯
荞麦皮枕芯、茶叶枕芯、药枕等一般具有保健功效,水洗易影响保健效果,还极易发霉。建议每隔一段时间,把荞麦皮、茶叶等倒出来,筛除碎屑,平摊开来放在阳光下晾晒。
羽绒枕芯
羽绒枕芯不宜机洗,水洗时先将枕芯放入冷水中浸泡20分钟,然后放到30℃温水中,加中性洗涤剂浸泡15分钟,再用软毛刷轻轻刷洗。也可加4-5汤勺白醋中和洗衣液。羽绒枕头不能直接暴晒。
乳胶枕芯
必须手洗。先用加有洗涤剂的冷水浸泡,然后用手轻压,再用清水冲净。洗后用干布吸水,放置在阴凉处风干。避免暴晒,使枕头提前老化。
3至少每 3 年换 1 次枕头
本身有呼吸道疾病、过敏的人群,最好1年左右换一次枕头。
没有基础性疾病的人,可以3年左右换一次枕头。
如果觉得我的文章对您有用,请随意打赏。你的支持将鼓励我继续创作!